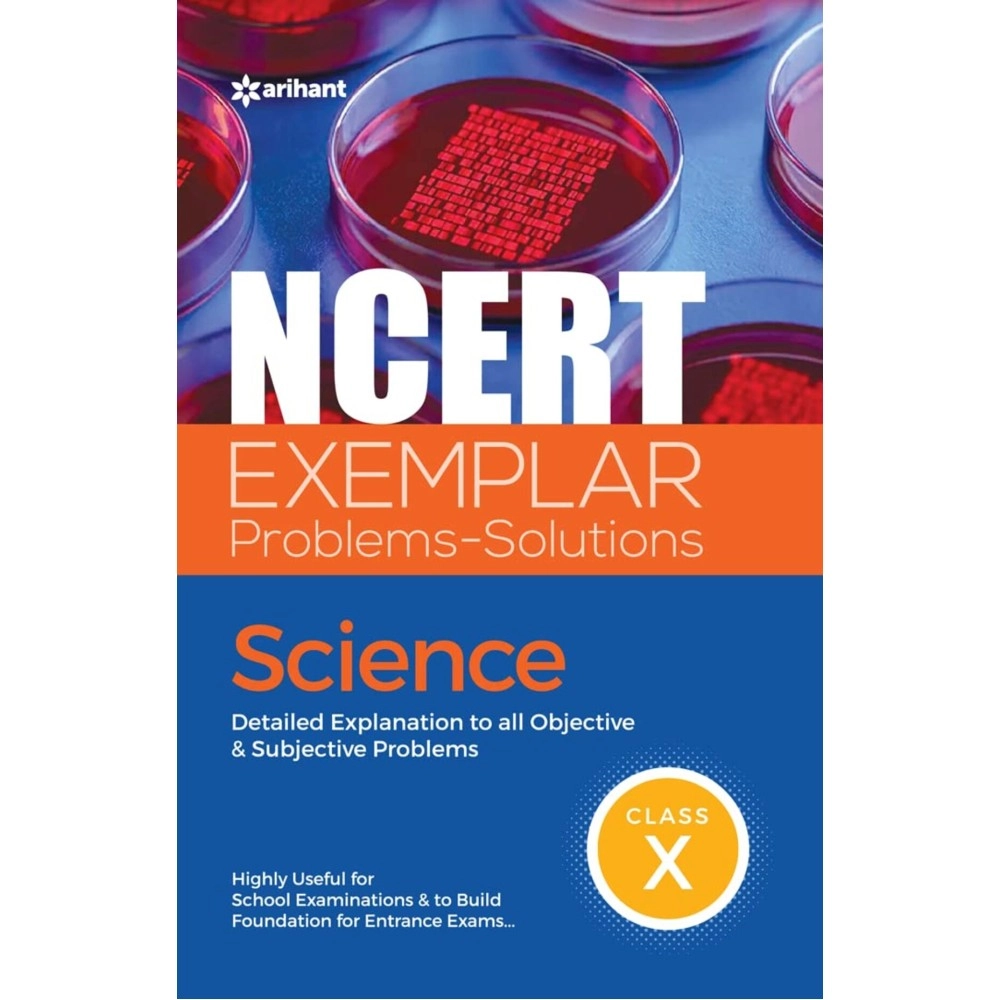
Arihant Publication India Limited NCERT Exemplar Problems-Solutions Science class 10th
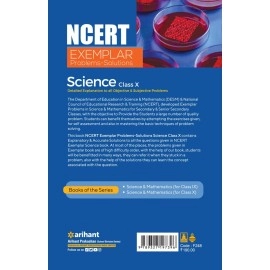
Arihant Publication India Limited NCERT Exemplar Problems-Solutions Science class 10th

Arihant Publication India Limited NCERT Exemplar Problems-Solutions Science class 10th
About this item
Estimated Delivery Date: Monday, 08 December to Wednesday, 10 December

Product Description
Product Features
| Product Specification | |
| SKU | INZ_9327197399 |
| Manufacturer | Arihant Publication India Limited |
| UPC | 9789327197396 |
| Weight | 500.00 |
| Diamention | 24.00 x 16.00 x 2.00 |
When you order from opencartworks.com, you will receive a confirmation email. Once your order is shipped, you will be emailed the tracking information for your order's shipment. You can choose your preferred shipping method on the Order Information page during the checkout process.
The total time it takes to receive your order is shown below:

The total delivery time is calculated from the time your order is placed until the time it is delivered to you. Total delivery time is broken down into processing time and shipping time.
Processing time: The time it takes to prepare your item(s) to ship from our warehouse. This includes preparing your items, performing quality checks, and packing for shipment.
Shipping time: The time for your item(s) to tarvel from our warehouse to your destination.
Shipping from your local warehouse is significantly faster. Some charges may apply.
In addition, the transit time depends on where you're located and where your package comes from. If you want to know more information, please contact the customer service. We will settle your problem as soon as possible. Enjoy shopping!